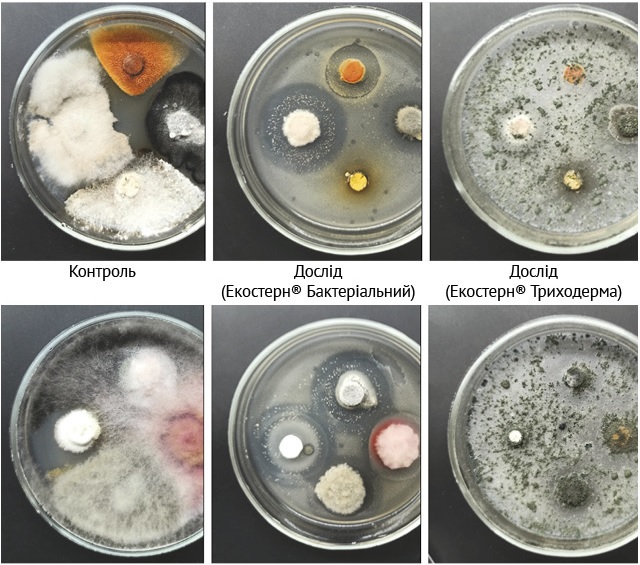

Звуження сівозмін і широке застосування агрохімікатів спричиняє формування пулу природних деструкторів — мікроорганізмів, які є патогенами до рослин і, розмножуючись і зимуючи на рештках відмерлих рослин попереднього року, інфікують рослини наступного вегетаційного сезону. Також загострюються алелопатичні прояви, в ґрунті нагромаджуються залишки пестицидів й інших ксенобіотиків. І саме ці наслідки порушення рівноваги в екосистемі важливо нівелювати. Спроба застосовувати хімічні засоби у цій ситуації тільки поглиблює дисбаланс.
Компанія БТУ-ЦЕНТР провела низку лабораторних і польових дослідів і дійшла висновку, що реальним і ефективним способом запуску відновлювальних процесів у екосистемі ґрунту є видове розширення мікробного ценозу. Це можливо завдяки внесенню агрономічно корисної мікробіоти, живі клітини якої входять до складу біологічних препаратів, зокрема деструкторів.
Деструктор Екостерн® — класика, перевірена часом
Деструктор ЕКОСТЕРН® КЛАСИЧНИЙ уже 8 років контролює деструкцію побічної продукції й рослинних решток на полях 1700 господарств по всій Україні, зокрема 15 потужних агрохолдингів (Kernel, «Контінентал Фармерз Груп», Vitagro, «ТАС АГРО» й ін.). Це унікальна розробка компанії БТУ-ЦЕНТР, якою користуються уже в 13 країнах світу.
До препарату входять мікроорганізми, що здатні пригнічувати патогени сільськогосподарських культур, деструктувати залишки ксенобіотиків, сприяти зниженню рівня фітотоксичності рослинних решток. Водночас ці біологічні агенти є достойними конкурентами патогенам в ніші, що відведена природою деструкторам і, забезпечує якісну деструкцію, сприяє збагаченню ґрунту гумусовими речовинами, поліпшує структуру ґрунту.
У 2021 році ЕКОСТЕРН® Класичний було підсилено новим комплексом мікроорганізмів. До оновленого складу входять 8 штамів роду Bacillus, Paenibacillus Polymyxa, 2 штами роду Azotobacter, Enterobacter, Enterococcus, Agrobacterium та 2 штами грибів роду Trichoderma. Вони є активними деструкторами рослинних решток, сприяють загальному поліпшенню фітосанітарного стану ґрунту та його біологічної активності.

Розумний підхід до кожного поля — деструктори для точного землеробства
Різні ґрунтові відміни, різні кліматичні умови й головне — різна інтенсивність сільськогосподарського застосування потребують постійного удосконалення формуляції Екостерн® з метою адаптації до різних умов використання препарату. Мікробіологи БТУ-ЦЕНТР розробили лінійку деструкторів для точного землеробства, нові композиції препарату дозволять сформувати індивідуальний, розумний підхід до кожного поля і господарства. У результаті отримали нові продукти.
Серед запропонованих нових марок є препарати з бактеріальною складовою — Екостерн® Бактеріальний, грибною складовою — Екостерн® Триходерма та комплексні — це Екостерн® Лайт, Екостерн® Ноу-тілл та Екостерн® Класичний.
Команда науковців БТУ-ЦЕНТР, маючи широку колекцію штамів агрономічно цінних мікроорганізмів, і далі провадить селекцію (відбір) нових, активніших штамів. Це надає можливість перманентно поліпшувати препарати.
Нові марки відрізняються від базової селективністю дії в агроценозі, залежно від умов застосування. Якщо базову марку Екостерн®, що містить спори бактерій і конідії грибів, виробник пропонує вносити влітку після збирання зернових чи восени після збирання кукурудзи, соняшнику, контролюючи температурний режим і реакцію середовища, то в нових композиціях Екостерн® ураховано особливості ґрунтово-кліматичних умов і розвиток агроценозу.
ЕКОСТЕРН® БАКТЕРІАЛЬНИЙ не має грибної складової, а тільки спори й цисти бактерій — активних деструкторів із широким спектром впливу на оздоровлення екосистеми ґрунту. Цей деструктор стійкий до несприятливих температурних умов, тому рекомендується застосовувати його в південно-східних регіонах країни, на територіях із ґрунтами підвищеної лужності (рН більше як 7) та за екстремальних температур довкілля. В умовах високих літніх (до +45 °С) та низьких осінніх температур ЕКОСТЕРН® БАКТЕРІАЛЬНИЙ ефективніший, як порівняти з іншими марками ЕКОСТЕРН®. Після внесення препарату в полі потрібно в перші 1–3 доби після застосування провести оранку або дискування. Деструкційна активність мікроорганізмів посилюється за внесення 5–15 кг/га д. р. азоту. Ця марка деструктора, маючи стабільні фізико-хімічні й біологічні властивості, є найзручнішою для бакових сумішей з агрохімікатами.
ЕКОСТЕРН® ТРИХОДЕРМА, навпаки, не містить бактерій і дозволяє захистити від ґрунтових патогенів і посилити деструкцію. До його складу входить від одного до чотирьох штамів активних грибів роду Trichoderma. Ця марка пропонується для застосування навесні та восени в рядок разом із сівбою культур із метою захисту сходів рослин й оздоровлення ґрунту, а також восени під культивацію чи боронування для забезпечення ефективної посиленої деструкції решток після збирання врожаю. За прогнозу погіршення фітосанітарного стану посівів препарат ЕКОСТЕРН® ТРИХОДЕРМА доцільно застосовувати фоліарно як для запобігання хвороб, так і за появи осередків ураження рослин.
Фунгіцидна активність Екостерн® Бактеріальний та Екостерн® Триходерма щодо фітопатогенів: Verticillium lateritium, Drechslera sorokiniana, Sclerotinia sclerotiorum, Botrytis cinereа, Nigrospora oryzae, Fusarium
ЕКОСТЕРН® НОУ-ТІЛЛ містить як бактеріальну компоненту, так і гриби. Оскільки в технологіях No-till, Strip-till, Mini-till відсутня можливість глибокого загортання препарату в ґрунт, то було запропоновано композицію зі штамів бактерій, які продукують більшу кількість слизу (полісахаридів), порівнюючи з іншими активними мікроорганізмами-деструкторами. Це дозволяє живій біологічній компоненті препарату краще закріплюватись на поверхні решток, а за посушливих умов концентрувати більшу кількість вологи. Перевага надавалась також штамам бактерій і грибів, що переважають інших за інтенсивністю синтезу проявів антагоністичних властивостей. Адже систематичне надходження маси рослинних решток на поверхню ґрунту і їх нагромадження передбачає можливість активізування патогенів. Азот додавати не потрібно.
ЕКОСТЕРН® ЛАЙТ — це пробіотик для ґрунту, який містить бактерії, гриби й неспорові форми, що продукують слиз. Він сприяє поліпшенню азотного живлення та підсиленню вологоутримувальної здатності завдяки композиції бактерій, що синтезують більше слизу і біологічно активних речовин, які сприяють нівелюванню алелопатичних проявів, деструктують залишки пестицидів, позитивно впливають на рослини в умовах стресу. Його рекомендують вносити влітку та ранньої осені. Тоді крім перелічених вище ефектів є можливість ще й поліпшити азотне живлення та підсилити вологоутримувальну здатність ґрунту. Препарат потрібно вносити вранці або ввечері з одночасним загортанням у ґрунт (дискування або оранка). Оптимальний діапазон температур для препарату: від +5 до +30 °С. Азотні добрива в дозі 0–10 кг/га д. р. підсилюють деструктивну здатність мікроорганізмів.
Інтенсивність деструкції — дослідження науковців
В Інституті прикладної біотехнології БТУ-ЦЕНТР 2020 року були проведені модельні й лабораторні дослідження різних марок Екостерн®. Інтенсивність деструкції визначали з використанням соломи пшениці й дерново-підзолистого ґрунту, який має слабкий рівень кислотності, високу забезпеченість фосфором і калієм, низьку — за азотом. Моделювали внесення 10 т/га соломи в шар ґрунту 0–10 см. Виявили, що за 30 днів компостування в посудинах із різними марками ЕКОСТЕРН® деструктувалось 25–31% соломи без додаткового внесення азоту та 36–43% — з азотом.
Антифунгальний вплив препаратів на найпоширеніших збудників хвороб у рослин продемонстровано на фото. Усі препарати пригнічували ріст і розвиток патогенних грибів.






